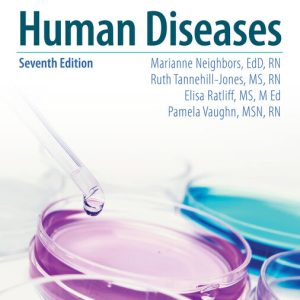
Human Diseases 7th Edition by Marianne Neighbors  Solution manual

Shop
Showing 613–624 of 1349 results
-
Nursing & Health
Human Diseases 7th Edition by Marianne Neighbors Solution manual
$35.00 Add to cart -
Uncategorized
Human Resource Management 17th edition Gary Dessler Instructor manual
$30.00 Add to cart